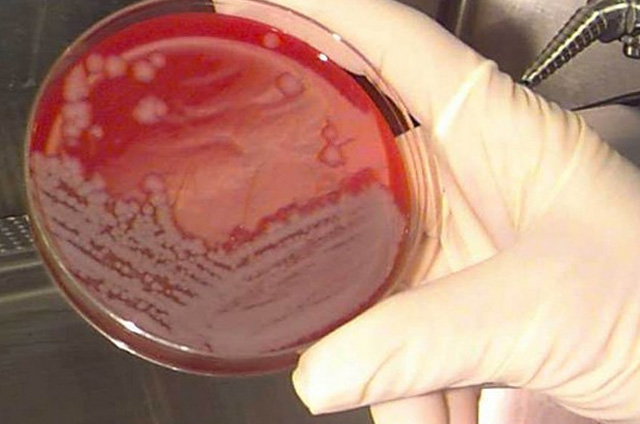

Američka vojska godinu dana greškom slala uzorke antraksa laboratorijima!?
Uzorci su dobiveni u Dugwayju, a zatim su odatle i iz Edgewooda slani američkim saveznim, privatnim i akademskim ustanovama, rekao je dužnosnik, dodajući da zasad nema opasnosti za stanovništvo
Dvije američke vojne ustanove, pokusni poligon u Dugwayju, u Utahu, i kemijsko-biološki centar Edgewood u Marylandu pogreškom su slali sumnjive uzorke živog antraksa od ožujka 2014. do travnja 2015., rekao je u srijedu američki dužnosnik, a prenosi agencija Reuters.
Dužnosnik koji je htio ostati neimenovan, rekao je da je vojni poligon u Dugwayju izvijestio, očito pogrešno, kako je gama zračenjem inaktivirao zalihe antraksa.
Uzorci su dobiveni u Dugwayju, a zatim su odatle i iz Edgewooda slani američkim saveznim, privatnim i akademskim ustanovama, rekao je dužnosnik, dodajući da zasad nema opasnosti za stanovništvo.
Pentagon je u srijedu objavio da je sumnjivi uzorak sa živim stanicama antraksa (bedrenice) poslan u američku bazu u Južnoj Koreji, uz uzorke koji su pogreškom poslani u devet američkih saveznih država, ali je istaknuo da nitko od osoblja ne pokazuje simptome mogućeg doticaja s bakterijom.
“Uzorak je uništen po zadanom protokolu”, rekao je glasnogovornik PentagonaSteve Warren, dodajući da je uzorak bio poslan u južnokorejsku zračnu bazu Osan.
Američke savezne vlasti su izdale preporuku da četiri civilne osobe u SAD-u preventivno uzmu lijek pošto je vojni laboratorij u Utahu pogreškom poslao poštom žive uzorke antraksa umjesto mrtvih, rekli su u srijedu američki dužnosnici.
Dužnosnik koji je htio ostati anoniman nije rekao o kakvom je lijeku riječ, samo da je to “preventivna profilaksa”.
Četiri osobe su izložene “minimalnom” riziku, rekao je Jason McDonald, glasnogovornik Američkih centara za kontrolu i prevenciju bolesti (CDC) koji su počeli istragu o tom izgredu. No one su “izvele proceduru kojom je agens dospio u zrak”, rekao je.
Kada antraks dospije u zrak može prouzročiti smrtonosnu bolest poznatu kao udisajni (plućni) antraks. Takav se slučaj dogodio 2001. kada je antraks poslan poštom američkoj vladi i medijima usmrtio pet ljudi.
Izgred se događa jedanaest mjeseci pošto je CDC, jedan od vladinih najboljih civilnih laboratorija, također pogrešno rukovao antraksom.
U najnovijem slučaju antraks je iz laboratorija u Utahu poslan u laboratorije u Marylandu, Teksasu, Wisconsinu, Delawareu, New Jerseyju, Tennesseeju, New Yorku, Kaliforniji i Virginiji, rekao je čelnik ministarstva obrane.
Barem jedan od tih laboratorija, onaj u Marylandu, otkrio je 22. svibnja aktivne bakterije u svom uzorku i upozorio vlasti, prenosi AFP.
Pokusni poligon u Dugwayju trenutačno sudjeluje u vojnom programu za izradu testova za otkrivanje biološke prijetnje koji bi se mogli primjenjivati na terenu, rekao je pukovnik Steven Warren, glasnogovornik Pentagona.
Ministarstvo obrane je “iz opreza obustavilo” slanje neaktivnih uzoraka “dok čeka rezultate istrage”, dodao je.
Antraks je akutna infekcija od koje obolijevaju životinje i ljudi. Uzročnik je bakterija Bacillius anthracis koja se može koristiti i kao bakteriološko oružje.
Dugway je u nadležnosti američke kopnene vojske. Radi na suzbijanju kemijskih, bioloških, radioaktivnih i eksplozivnih prijetnja, piše na njegovoj mrežnoj stranici.

